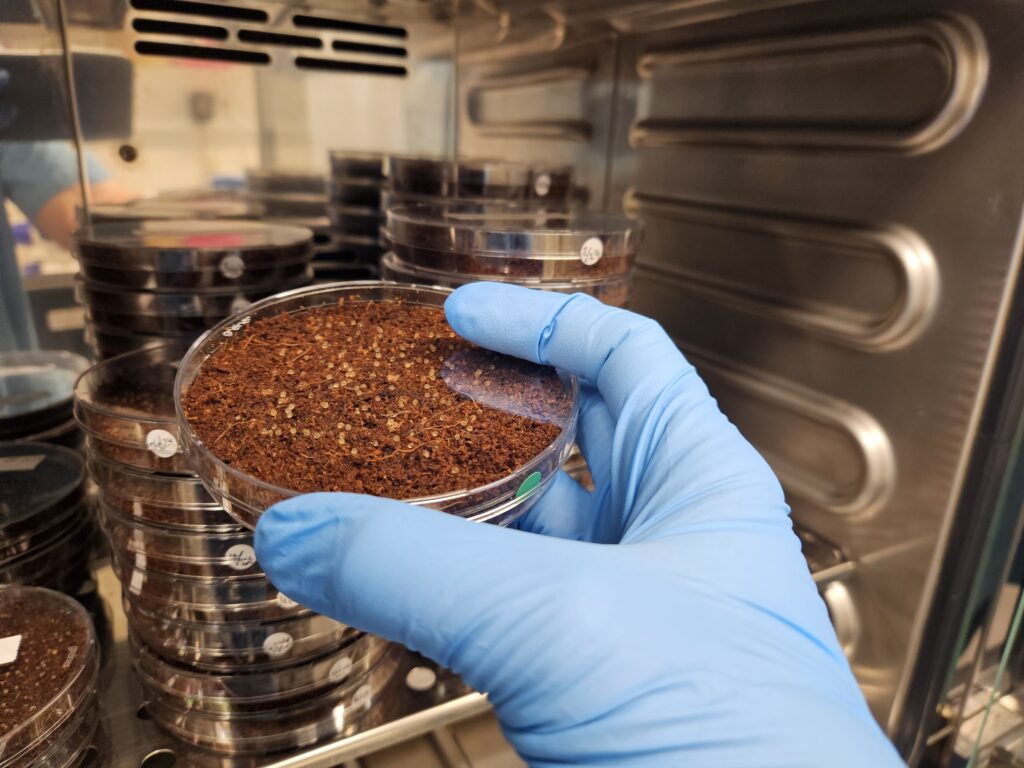

Bionomous releases Sortivo™, a new automated platform to handle complex biological models and accelerate NAMs adoption

Bionomous new automated solution Bionomous, the Swiss-based startup that builds devices to automate processes in life science research, announces today the launch of its new platform, Sortivo™. The device automates the screening, sorting and plating of complex biological entities from 300 µm to ~2 mm such as zebrafish embryos and organoids, workflows that, until now, […]
Application note – Intelligent Automation for Advanced 3D Models

Would you like to automate your organoids workflows to standardise and scale your assays? Three-dimensional (3D) cell culture models are transforming biomedical research by enabling in vitro physiologically relevant systems that better mimic native tissue structure and function. While constructs generation technologies have advanced significantly, downstream processes such as selection, characterization, and plating often remain […]
Bionomous partners with ViewPoint for the distribution of the EggSorter

Exciting collaboration between ViewPoint and Bionomous! We are thrilled to announce a new partnership between ViewPoint and Bionomous for the distribution of Bionomous’ products! ViewPoint is a French company with offices in France, the US and China that specializes in video image processing for animal behavior analysis. By leveraging its 30 years of expertise, ViewPoint […]
Application note – LabSwipe: AI for sorting

Would you like to know how LabSwipe can help you create custom AI algorithms for your sorting? This application note explains four different use cases where LabSwipe has been used to create custom sorting algorithms. Results demonstrate over 90% accuracy in the created algorithms for all the studied cases. This application note explains four different […]
BIONOMOUS changes the composition of its Board of Directors and onboards its new Chief Business Officer

Bionomous New Board Organization and Onboarding of the New Chief Business Officer Bionomous, the Swiss-based startup that builds devices to automate processes in Life Science Research, announces today strategic changes to its Board of Directors and executive team, effective March 27th, 2025. These appointments come at a pivotal time as the company accelerates its commercial expansion, […]
Bionomous Secures Technology Fund Loan to Advance Sustainable – Press Release

Bionomous, a leading innovator in automated screening and sorting technologies, is pleased to announce that it has received significant support from Switzerland’s Technology Fund in the form of a loan guarantee. This strategic financing will support the deployment of Bionomous’ automated sorting solutions, which are designed to offer sustainable impact across various industries, including research […]
Application note – Sorting of killifish (N. furzeri) embryos with the EggSorter
Do you work with killifish and you would like to know how the EggSorter can benefit your lab? This application note explains how the fish facility at the Leibniz Institute on Aging uses the EggSorter for the automatic sorting of killifish embryos. Results demonstrate that the use of the EggSorter ensures more consistent and standardized handling […]
Bionomous has received the Innosuisse Scale-up award!

We are proud to announce that we have received the Innosuisse Scale-up Award ! ???? This means that we passed to the second phase of the Scale-up Coaching Programme. This milestone opens us the doors for accelerated growth in Switzerland and expansion into new global markets . Stay tuned for updates as we continue this […]
Bionomous has been chosen for the prestigious Zühlke Product Scale-up Coaching program

We are thrilled to announce that our company has been chosen for the prestigious Zühlke Product Scale-up Coaching program. This incredible opportunity will provide us with expert guidance and strategic insights to accelerate our product growth and innovation. This program has been organised in partnership with Venturelab, and we want to give a big thank […]
White paper – Is the EggSorter biocompatible with Zebrafish embryos?

Have you ever thought of the impact of the EggSorter in the development of your zebrafish embryos? This white paper presents a set of trials evaluating the safety and efficacy of the EggSorter in standardising the sorting process of zebrafish embryos. Results demonstrate that the use of the EggSorter does not induce adverse effects on […]